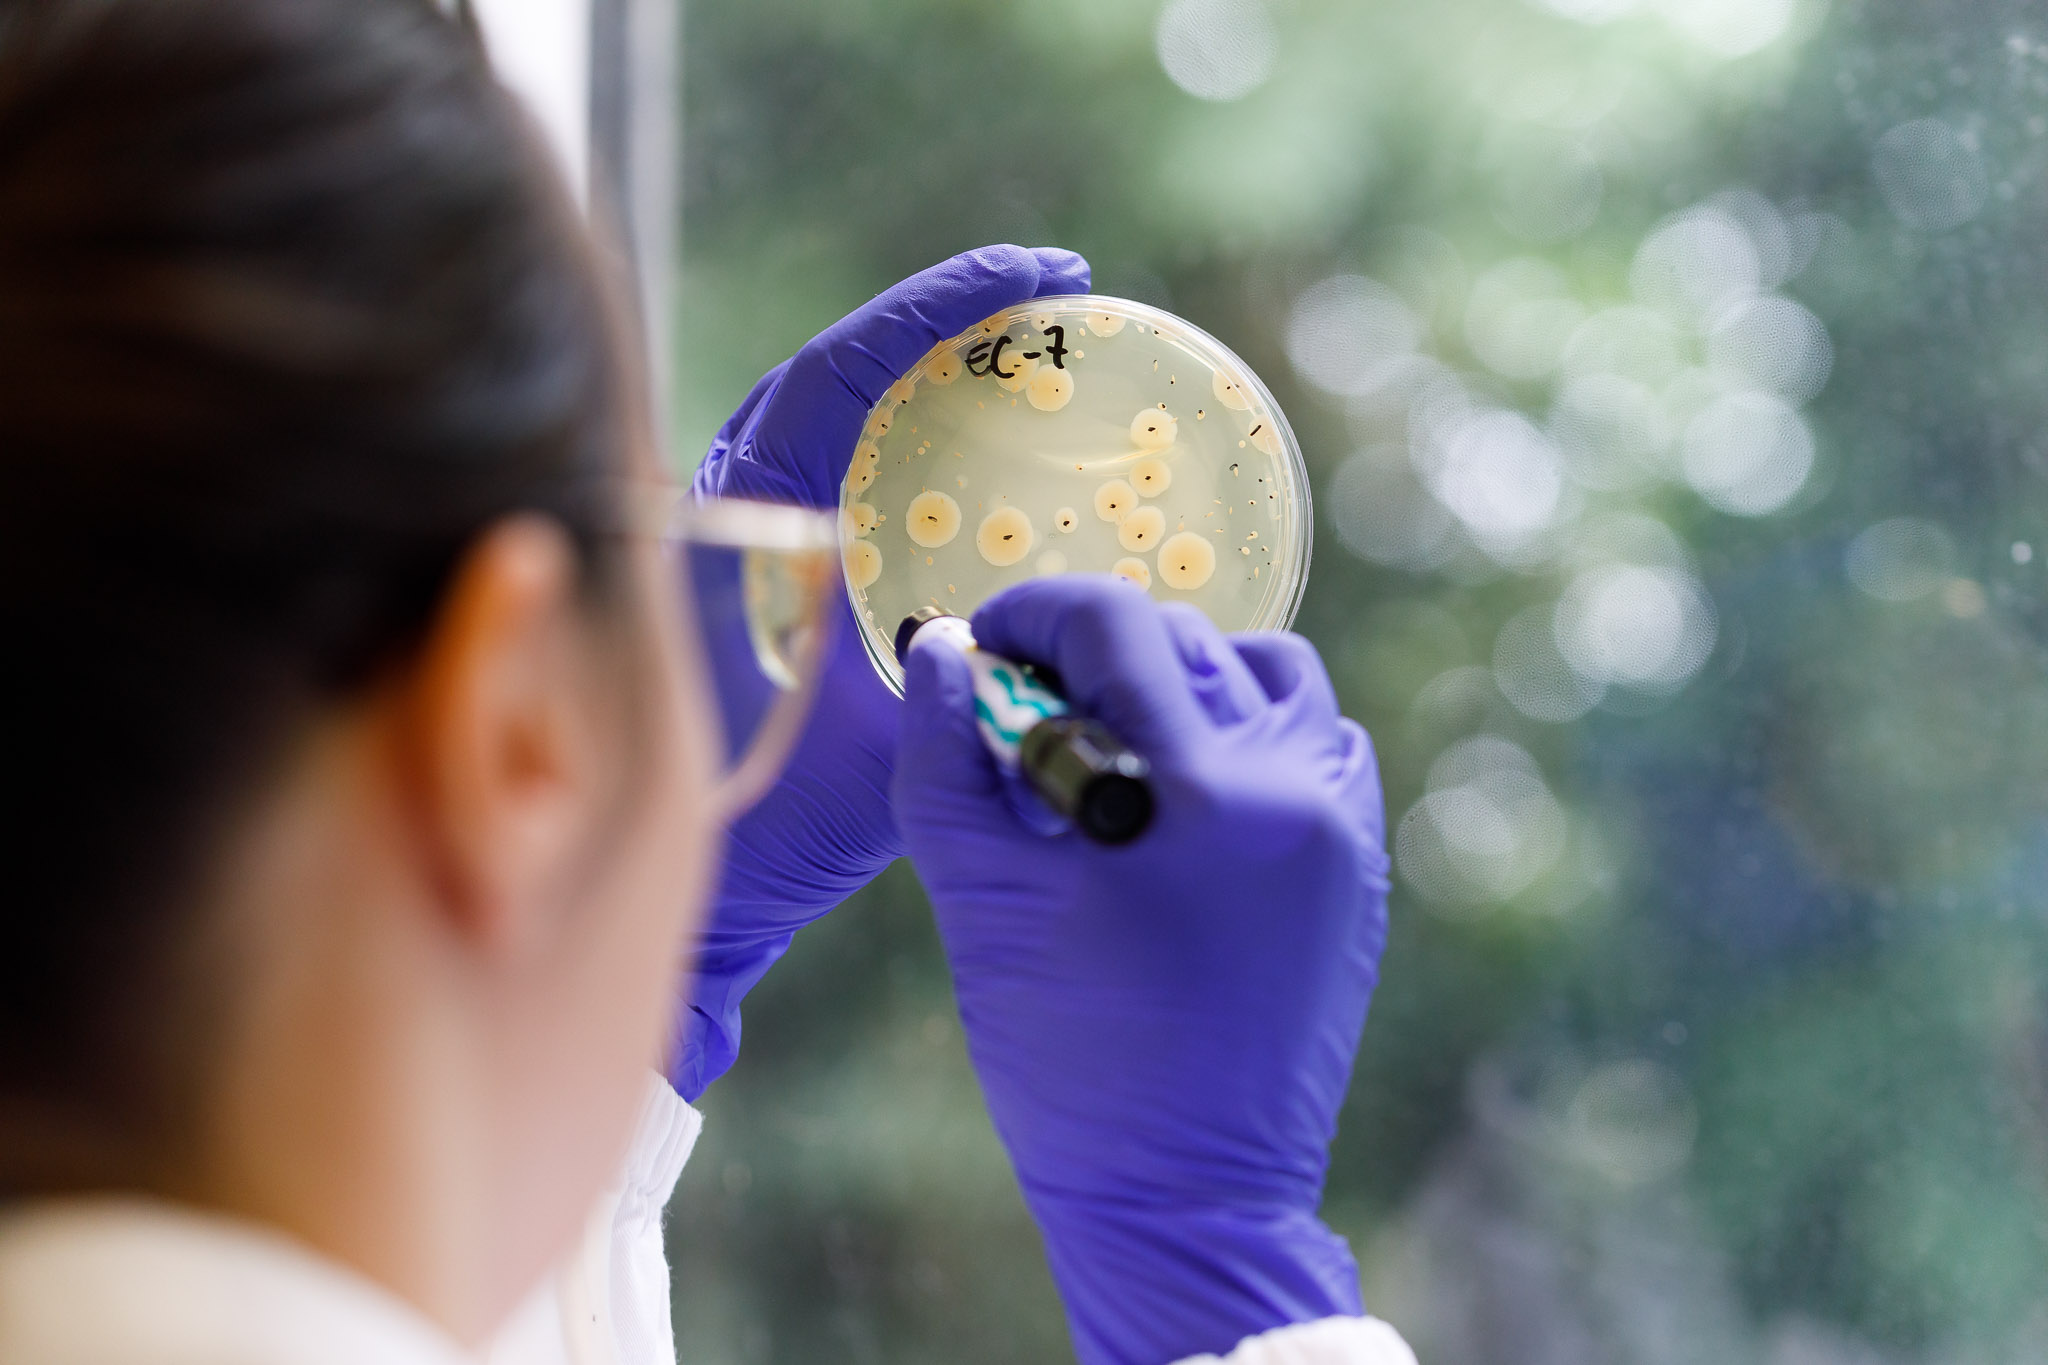

Bio Basic
Bio Basic accompagna le aziende nel percorso che trasforma un’idea, in un prodotto sicuro, efficace e pronto per il mercato.
Siamo una realtà di riferimento nelle valutazioni di sicurezza ed efficacia di prodotti dermocosmetici, solari, integratori alimentari, dispositivi medici, detergenza e molte altre categorie.
Ogni giorno mettiamo in campo competenze scientifiche e visione strategica per offrire test clinici e di laboratorio, consulenza tecnico-scientifica, supporto regolatorio e marketing, affiancando clienti in Italia e all’estero con la stessa attenzione e passione per la qualità.

Ogni settore ha le sue regole, i suoi ritmi e le sue sfide. Noi di Bio Basic li conosciamo da vicino, perché da oltre trent’anni lavoriamo accanto alle aziende che innovano nei mondi della cosmetica, degli integratori alimentari, dei solari, dei dispositivi medici e prodotti per la detergenza.
In ciascuno di questi ambiti offriamo competenze tecnico-scientifiche, supporto regolatorio e attività di testing per accompagnare le aziende in ogni fase del ciclo di vita del prodotto, dallo sviluppo alla validazione, fino alla sorveglianza post-market.
Il nostro obiettivo è semplice ma ambizioso: trasformare la complessità normativa e scientifica in un percorso chiaro, concreto e su misura, che aiuti i nostri clienti a crescere in modo sicuro e sostenibile.
LE RADICI
Nascita
BIO BASIC nasce a Milano da un team di specialisti operanti nei settori cosmetico e farmaceutico
Espansione
BIO BASIC in un primo periodo offre servizi di consulenza tecnica ed in seguito sviluppa accordi con Istituti Universitari per la realizzazione di test di sicurezza su prodotti cosmetici
R&D
BIO BASIC si dota delle attrezzature e delle risorse necessarie per svolgere al proprio interno attività R&D di elevato standard:
• CDC (Istituto di Ricerche Dermo-Cliniche)
• BIO BASIC LAB
Ampliamento
Centro logistico smistamento campioni
da 100 m2 a 500 m2
Espansione laboratorio
Ampliamento degli spazi di Bio Basic Lab
da 190 m2 a 350m2
Rebranding
BIO BASIC si rinnova con una nuova immagine coordinata
MISSION
Garantire la sicurezza, l’efficacia e la conformità di prodotti cosmetici, dispositivi medici e integratori alimentari attraverso test scientifici avanzati e supporto regolatorio qualificato. Grazie a un investimento costante in formazione e ricerca, alle collaborazioni con Università, fondazioni e istituti ospedalieri e all’adeguamento del sistema Gestione Qualità in conformità agli standard UNI CEI EN ISO/IEC 17025 e UNI EN ISO 9001, BIO BASIC assicura risultati tracciabili, affidabili e certificabili. BIO BASIC si propone, quindi, di accompagnare le Aziende nella fase più delicata del ciclo di vita del prodotto, assicurando la validazione oggettiva delle performance, il rispetto delle normative e una comunicazione trasparente verso il mercato.

VISION
Trusted. Tested. Certified. In un mercato regolato, ad alta specializzazione e guidato da innovazione, precisione e conformità, il valore di un prodotto si misura nella capacità di dimostrarne la sicurezza, l’efficacia e la solidità scientifica. BIO BASIC immagina un ecosistema in cui ogni formula, ogni claim, ogni immissione sul mercato sia sostenuta da dati tracciabili, test rigorosi e validazioni indipendenti. Un futuro in cui le aziende possono innovare responsabilmente, comunicare con credibilità e operare secondo i più alti standard di qualità e compliance. Promuovendo una cultura della prova oggettiva, BIO BASIC si fa ambasciatore di un modello evoluto e affidabile di sviluppo: dove scienza, etica e trasparenza diventano motore di progresso per l’intera filiera.
LE 4 PASSION DI BIO BASIC
PASSION FOR QUALITY
Mettiamo l'eccellenza al centro di ogni nostra attività, unendo competenza tecnica e precisione metodologica per garantire standard qualitativi superiori in tutti i nostri servizi. Ci impegniamo in un costante processo di miglioramento, investendo nella ricerca scientifica e nell'ottimizzazione dei processi aziendali. La nostra indipendenza e neutralità scientifica sono il fondamento della credibilità che ci viene riconosciuta, assicurando ai nostri clienti la massima affidabilità e risultati verificabili.
PASSION FOR RESULTS
Orientiamo ogni azione al raggiungimento di risultati concreti e misurabili con un forte focus sul business. La nostra pianificazione metodica e la proattività sono gli strumenti che ci permettono di trasformare le sfide in opportunità di crescita. Agiamo con responsabilità nei confronti di clienti, collaboratori e consumatori finali, rispettando rigorosamente tutte le normative di settore e garantendo trasparenza in ogni fase del nostro lavoro.
PASSION FOR PEOPLE
Crediamo nello sviluppo continuo delle competenze e nel potenziale di ogni persona. Promuoviamo un ambiente di lavoro dove ciascuno può esprimere il proprio talento, contribuire con nuove idee e crescere professionalmente. Valorizziamo il contributo di ciascuno e favoriamo un dialogo aperto, costruttivo e rispettoso. Investiamo nella formazione e nel benessere dei nostri collaboratori, favorendo un equilibrio sano tra vita professionale e personale.
PASSION FOR RELATIONSHIPS
Costruiamo partnership durature basate sulla fiducia, attraverso trasparenza ed etica professionale. Adottiamo un approccio consulenziale personalizzato, supportando i clienti durante l'intero percorso per garantire il successo dei loro progetti. Creiamo sinergie tra le diverse aree aziendali e con i nostri partner esterni, favorendo la collaborazione e la condivisione delle competenze a tutti i livelli dell'organizzazione per raggiungere insieme obiettivi comuni e superare le aspettative.


